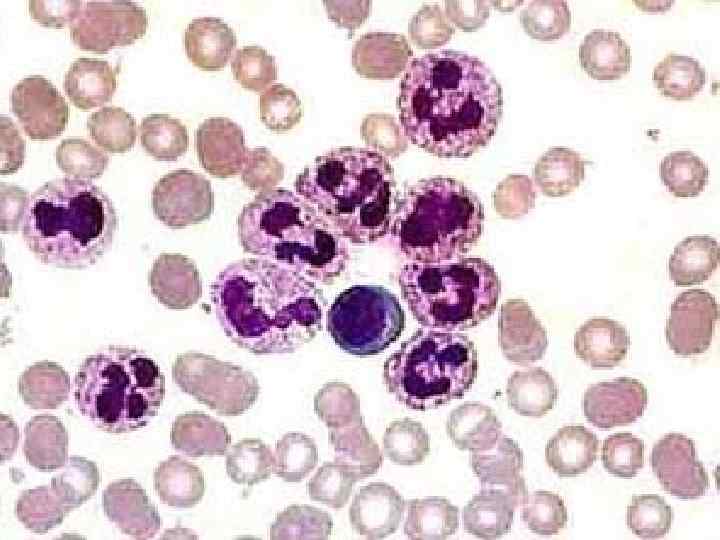
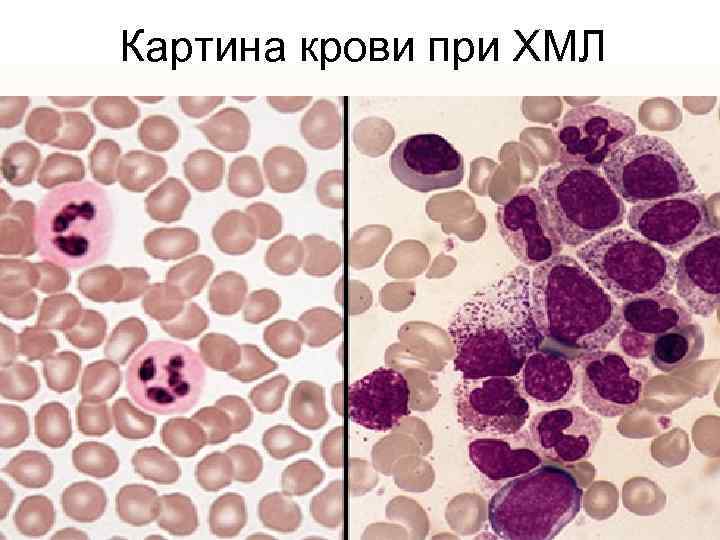
Картина крови при ХМЛ
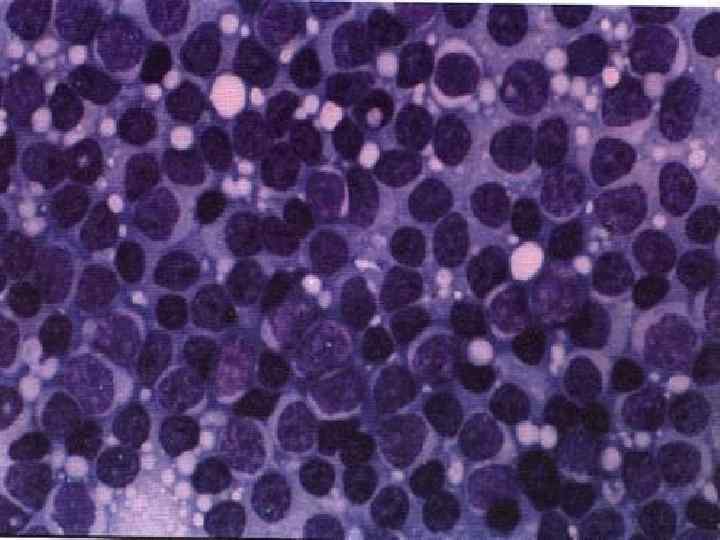

SP_v_terapii_40_Leykozy.ppt
- Количество слайдов: 51
 СП при лейкозах. СП в терапии, лекция № 40
СП при лейкозах. СП в терапии, лекция № 40
 Лейкоз – злокачественное системное заболевание крови (рак крови), характеризующееся следующими особенностями: • 1) поражением органов кроветворения – костного мозга, лимфоузлов, селезенки; • 2) безудержным, метапластическим разрастанием недифференцированных, юных клеток белой крови (лейкоцитов и их предшественников).
Лейкоз – злокачественное системное заболевание крови (рак крови), характеризующееся следующими особенностями: • 1) поражением органов кроветворения – костного мозга, лимфоузлов, селезенки; • 2) безудержным, метапластическим разрастанием недифференцированных, юных клеток белой крови (лейкоцитов и их предшественников).


 Размножение лейкозных клеток
Размножение лейкозных клеток
 Классификация лейкозов В клинической практике в основном встречаются три формы лейкозов: 1. Острый недифференцированноклеточный (до 50% случае) (Острый лейкоз) 2. Хронический лимфаденоз (до 25% случаев) (Хронический лимфолейкоз) 3. Хронический миелоз (до 25% случаев) (Хронический миелолейкоз) Таким образом, на все остальные формы лейкозов приходится не более 1 -2% случаев.
Классификация лейкозов В клинической практике в основном встречаются три формы лейкозов: 1. Острый недифференцированноклеточный (до 50% случае) (Острый лейкоз) 2. Хронический лимфаденоз (до 25% случаев) (Хронический лимфолейкоз) 3. Хронический миелоз (до 25% случаев) (Хронический миелолейкоз) Таким образом, на все остальные формы лейкозов приходится не более 1 -2% случаев.
 Этиологические факторы лейкоза • 1 группа -- инфекционно-вирусные причины; • 2 группа -- наследственные факторы: подтверждается наблюдением за семьями, где один из родителей болен лейкозом; по статистике, есть или прямые, или через одно поколение передачи лейкоза. • 3 группа -- действие химических лейкозогенных факторов (канцерогенов): цитостатики при лечении онкозаболеваний, антибиотики пенициллинового ряда и цефалоспорины. Химические вещества промышленного и бытового назначения (ковровые покрытия, линолеум, синтетические моющие средства и т. д. ) • 4 группа -- лучевое воздействие (Хиросима, Фукусима, Чернобыль).
Этиологические факторы лейкоза • 1 группа -- инфекционно-вирусные причины; • 2 группа -- наследственные факторы: подтверждается наблюдением за семьями, где один из родителей болен лейкозом; по статистике, есть или прямые, или через одно поколение передачи лейкоза. • 3 группа -- действие химических лейкозогенных факторов (канцерогенов): цитостатики при лечении онкозаболеваний, антибиотики пенициллинового ряда и цефалоспорины. Химические вещества промышленного и бытового назначения (ковровые покрытия, линолеум, синтетические моющие средства и т. д. ) • 4 группа -- лучевое воздействие (Хиросима, Фукусима, Чернобыль).
 Вирус Эпштейна—Барра – еще одна разновидность герпеса
Вирус Эпштейна—Барра – еще одна разновидность герпеса
 Наследственные факторы
Наследственные факторы
 Цитостатики – противоопухолевые препараты
Цитостатики – противоопухолевые препараты
 Синтетические моющие средства
Синтетические моющие средства
 Авария на АЭС "Фукусима-1"
Авария на АЭС "Фукусима-1"
Острый лейкоз • Острый лейкоз представляет собой злокачественную опухоль системы крови. • Основной субстрат опухоли составляют молодые, так называемые бластные клетки. • В зависимости от морфологии и цитохимических показателей клеток в группе острых лейкозов выделяют: острый миелобластный лейкоз, монобластный, промиелоцитарный, лимфобластный, недифференцированный лейкоз.
Острый лейкоз • Острый лейкоз представляет собой злокачественную опухоль системы крови. • Основной субстрат опухоли составляют молодые, так называемые бластные клетки. • В зависимости от морфологии и цитохимических показателей клеток в группе острых лейкозов выделяют: острый миелобластный лейкоз, монобластный, промиелоцитарный, лимфобластный, недифференцированный лейкоз.


 Клиника острого лейкоза • Анемический синдром: бледность, одышка, сердцебиение, сонливость. • Склонность к инфекциям (бактериальным, грибковым и вирусным). • Геморрагический синдром - петехии и экхимозы на коже, тяжёлые носовые и внутренние кровотечения. • Интоксикация: лихорадка, похудение, снижение аппетита, слабость и т. п. • Гепато и спленомегалия. • Лимфаденопатия. • Гипертрофия дёсен, стоматиты и ангины.
Клиника острого лейкоза • Анемический синдром: бледность, одышка, сердцебиение, сонливость. • Склонность к инфекциям (бактериальным, грибковым и вирусным). • Геморрагический синдром - петехии и экхимозы на коже, тяжёлые носовые и внутренние кровотечения. • Интоксикация: лихорадка, похудение, снижение аппетита, слабость и т. п. • Гепато и спленомегалия. • Лимфаденопатия. • Гипертрофия дёсен, стоматиты и ангины.
 В течение острого лейкоза выделяется несколько стадий: • 1) начальная; • 2) развернутая; • 3) ремиссия (полная или неполная); • 4) рецидив; • 5) терминальная.
В течение острого лейкоза выделяется несколько стадий: • 1) начальная; • 2) развернутая; • 3) ремиссия (полная или неполная); • 4) рецидив; • 5) терминальная.
 Начальная стадия острого лейкоза • Начальная стадия острого лейкоза диагностируется чаще всего тогда, когда у больных с предшествующей анемией в дальнейшем развивается картина острого лейкоза.
Начальная стадия острого лейкоза • Начальная стадия острого лейкоза диагностируется чаще всего тогда, когда у больных с предшествующей анемией в дальнейшем развивается картина острого лейкоза.
 Развернутая стадия • Развернутая стадия характеризуется наличием основных клинических и гематологических проявлений заболевания.
Развернутая стадия • Развернутая стадия характеризуется наличием основных клинических и гематологических проявлений заболевания.
 Ремиссия • Ремиссия может быть полной или неполной. • К полной ремиссии относятся состояния, при которых отсутствуют клинические симптомы заболевания, количество бластных клеток в костном мозге не превышает 5 % при отсутствии их в крови. Состав периферической крови близок к норме. • При неполной ремиссии имеет место отчетливое клиническое и гематологическое улучшение, однако количество бластных клеток в костном мозге остается повышенным.
Ремиссия • Ремиссия может быть полной или неполной. • К полной ремиссии относятся состояния, при которых отсутствуют клинические симптомы заболевания, количество бластных клеток в костном мозге не превышает 5 % при отсутствии их в крови. Состав периферической крови близок к норме. • При неполной ремиссии имеет место отчетливое клиническое и гематологическое улучшение, однако количество бластных клеток в костном мозге остается повышенным.
 Рецидив • Рецидив острого лейкоза может возникать в костном мозге или вне костного мозга (кожа и т. д. ). • Каждый последующий рецидив прогностически более опасен, чем предыдущий
Рецидив • Рецидив острого лейкоза может возникать в костном мозге или вне костного мозга (кожа и т. д. ). • Каждый последующий рецидив прогностически более опасен, чем предыдущий
 Терминальная стадия • Терминальная стадия острого лейкоза характеризуется резистентностью к цитостатической терапии, выраженным угнетением нормального кроветворения, развитием язвеннонекротических процессов.
Терминальная стадия • Терминальная стадия острого лейкоза характеризуется резистентностью к цитостатической терапии, выраженным угнетением нормального кроветворения, развитием язвеннонекротических процессов.



 Хронический миелолейкоз • В крови появляются в большом количестве созревающие и зрелые клетки гранулоцитарного ряда (метамиелоциты, палочкоядерные и сегментоядерные гранулоциты). • Заболевание -- одно из самых частых в группе лейкозов, встречается у лиц в возрасте 20 --60 лет, редко у стариков и детей и длится годами.
Хронический миелолейкоз • В крови появляются в большом количестве созревающие и зрелые клетки гранулоцитарного ряда (метамиелоциты, палочкоядерные и сегментоядерные гранулоциты). • Заболевание -- одно из самых частых в группе лейкозов, встречается у лиц в возрасте 20 --60 лет, редко у стариков и детей и длится годами.

Картина крови при ХМЛ
Картина крови при ХМЛ
 Клиническая картина зависит от стадии заболевания. • Выделяют 3 стадии хронического миелолейкоза -- начальную, развернутую и терминальную.
Клиническая картина зависит от стадии заболевания. • Выделяют 3 стадии хронического миелолейкоза -- начальную, развернутую и терминальную.
 Начальная стадия хронического миелолейкоза • В начальной стадии хронический миелолейкоз практически не диагностируется или выявляется при случайном исследовании крови, поскольку симптоматика в этот период почти отсутствует. • Обращает на себя внимание постоянный и немотивированный лейкоцитоз с нейтрофильным профилем, сдвигом влево. • Увеличивается селезенка, что вызывает неприятные ощущения в левом подреберье, чувство тяжести, особенно после еды.
Начальная стадия хронического миелолейкоза • В начальной стадии хронический миелолейкоз практически не диагностируется или выявляется при случайном исследовании крови, поскольку симптоматика в этот период почти отсутствует. • Обращает на себя внимание постоянный и немотивированный лейкоцитоз с нейтрофильным профилем, сдвигом влево. • Увеличивается селезенка, что вызывает неприятные ощущения в левом подреберье, чувство тяжести, особенно после еды.
 Развернутая стадия хронического миелолейкоза • Развернутая стадия характеризуется появлением клинических признаков заболевания, связанных с лейкемическим процессом. • Больные отмечают быструю утомляемость, потливость, субфебрильную температуру, потерю веса. • Появляются тяжесть и боли в левом подреберье, особенно после ходьбы. • При объективном исследовании почти постоянным признаком является увеличение селезенки. • При пальпации селезенка остается безболезненной.
Развернутая стадия хронического миелолейкоза • Развернутая стадия характеризуется появлением клинических признаков заболевания, связанных с лейкемическим процессом. • Больные отмечают быструю утомляемость, потливость, субфебрильную температуру, потерю веса. • Появляются тяжесть и боли в левом подреберье, особенно после ходьбы. • При объективном исследовании почти постоянным признаком является увеличение селезенки. • При пальпации селезенка остается безболезненной.
 Терминальная стадия хронического миелолейкоза • В терминальной стадии отмечается резкое ухудшение общего состояния, усиление потливости, стойкое немотивированное повышение температуры. • Появляются сильные боли в костях и суставах. • Важным признаком является появление рефрактерности к проводимой терапии. • Значительно увеличена селезенка. Нарастает анемия, тромбоцитопения. • В терминальной стадии больные склонны к развитию инфекционных осложнений, которые нередко являются причиной смерти.
Терминальная стадия хронического миелолейкоза • В терминальной стадии отмечается резкое ухудшение общего состояния, усиление потливости, стойкое немотивированное повышение температуры. • Появляются сильные боли в костях и суставах. • Важным признаком является появление рефрактерности к проводимой терапии. • Значительно увеличена селезенка. Нарастает анемия, тромбоцитопения. • В терминальной стадии больные склонны к развитию инфекционных осложнений, которые нередко являются причиной смерти.
 Хронический лимфолейкоз • Хронический лимфолейкоз представляет собой доброкачественное опухолевое заболевание лимфоидной (иммунокомпетентной) ткани, не обнаруживающую, в отличие от других форм лейкозов, опухолевой прогрессии на всем протяжении болезни. • Основным морфологическим субстратом опухоли являются зрелые лимфоциты, которые разрастаются и накапливаются в повышенном количестве в лимфатических узлах, селезенке, печени, костном мозге.
Хронический лимфолейкоз • Хронический лимфолейкоз представляет собой доброкачественное опухолевое заболевание лимфоидной (иммунокомпетентной) ткани, не обнаруживающую, в отличие от других форм лейкозов, опухолевой прогрессии на всем протяжении болезни. • Основным морфологическим субстратом опухоли являются зрелые лимфоциты, которые разрастаются и накапливаются в повышенном количестве в лимфатических узлах, селезенке, печени, костном мозге.
Выделяют несколько форм хронического лимфолейкоза: 1) типичная доброкачественная форма с увеличением лимфоузлов, умеренной гепатоспленомегалией, лейкемической картиной крови, отсутствием анемии. 2) злокачественный вариант, отличающийся тяжелым течением, наличием плотных лимфоузлов, образующих конгломераты, высоким лейкоцитозом, частыми инфекционными осложнениями; 3) спленомегалическая форма, протекающая без периферических лимфаденопатий, с увеличением брюшных лимфоузлов. 4) костномозговая форма с изолированным поражением костного мозга, лейкемической картиной крови, отсутствием увеличения лимфоузлов и селезенки. 5) кожная форма протекает с преимущественной лейкемической инфильтрацией кожи;
Выделяют несколько форм хронического лимфолейкоза: 1) типичная доброкачественная форма с увеличением лимфоузлов, умеренной гепатоспленомегалией, лейкемической картиной крови, отсутствием анемии. 2) злокачественный вариант, отличающийся тяжелым течением, наличием плотных лимфоузлов, образующих конгломераты, высоким лейкоцитозом, частыми инфекционными осложнениями; 3) спленомегалическая форма, протекающая без периферических лимфаденопатий, с увеличением брюшных лимфоузлов. 4) костномозговая форма с изолированным поражением костного мозга, лейкемической картиной крови, отсутствием увеличения лимфоузлов и селезенки. 5) кожная форма протекает с преимущественной лейкемической инфильтрацией кожи;
 Обширная гематома у пациента с хроническим лимфолейкозом
Обширная гематома у пациента с хроническим лимфолейкозом
 Лечение лейкозов • Цитостатики – циклофосфан, лейкеран. • Полихимиотерапия – циклофосфан+ винкристин+ преднизолон (ЦВПтерапия). • Лучевая терапия. • Спленэктомия.
Лечение лейкозов • Цитостатики – циклофосфан, лейкеран. • Полихимиотерапия – циклофосфан+ винкристин+ преднизолон (ЦВПтерапия). • Лучевая терапия. • Спленэктомия.


 Общие рекомендации, фитотерапия • Всем больным лейкозами рекомендуется рациональный режим труда и отдыха, питание с высоким содержанием животного белка (до 120 г), витаминов и ограничением жиров (до 40 г). В рационе должны быть свежие овощи, фрукты, ягоды, свежая зелень. • Практически все лейкозы сопровождаются анемиями, поэтому рекомендуется фитотерапия, богатая железом, аскорбиновой кислотой.
Общие рекомендации, фитотерапия • Всем больным лейкозами рекомендуется рациональный режим труда и отдыха, питание с высоким содержанием животного белка (до 120 г), витаминов и ограничением жиров (до 40 г). В рационе должны быть свежие овощи, фрукты, ягоды, свежая зелень. • Практически все лейкозы сопровождаются анемиями, поэтому рекомендуется фитотерапия, богатая железом, аскорбиновой кислотой.


 Сестринский процесс при лейкозах Проблема Действия медсестры Потенциальная угроза здоровью, Провести беседу с пациентом о его связанная с дефицитом информации заболевании, предупреждении о своем заболевании возможных осложнений и профилактике обострений. Обеспечить пациента необходимой научно популярной литературой Трудности в принятии изменений диеты в связи со сложившимися ранее привычками Провести беседу с пациентом о значении и влиянии диетического питания на течение болезни и выздоровление.
Сестринский процесс при лейкозах Проблема Действия медсестры Потенциальная угроза здоровью, Провести беседу с пациентом о его связанная с дефицитом информации заболевании, предупреждении о своем заболевании возможных осложнений и профилактике обострений. Обеспечить пациента необходимой научно популярной литературой Трудности в принятии изменений диеты в связи со сложившимися ранее привычками Провести беседу с пациентом о значении и влиянии диетического питания на течение болезни и выздоровление.
 Риск падения из-за слабости, головокружения, высокой температуры; нарушений координации и онемения конечностей Оказывать помощь пациенту в выполнении мероприятий по личной гигиене. Обеспечить средствами связи с медперсоналом Тошнота, изменение вкуса Следить, чтобы пациент получал любимые блюда и красиво оформленные. Провести беседу с родственниками пациента о характере передач. Рекомендовать принимать пищу маленькими порциями, но часто Слабость, быстрая утомляемость Проводить контроль за соблюдением пациентом предписанного врачом режима двигательной активности. Затруднения глотания из-за болей в горле Рекомендовать принимать жидкую и полужидкую пищу маленькими порциями, но часто. Проводить контроль за своевременным приемом пациентом лекарственных препаратов. Обеспечить уход за полостью рта пациента
Риск падения из-за слабости, головокружения, высокой температуры; нарушений координации и онемения конечностей Оказывать помощь пациенту в выполнении мероприятий по личной гигиене. Обеспечить средствами связи с медперсоналом Тошнота, изменение вкуса Следить, чтобы пациент получал любимые блюда и красиво оформленные. Провести беседу с родственниками пациента о характере передач. Рекомендовать принимать пищу маленькими порциями, но часто Слабость, быстрая утомляемость Проводить контроль за соблюдением пациентом предписанного врачом режима двигательной активности. Затруднения глотания из-за болей в горле Рекомендовать принимать жидкую и полужидкую пищу маленькими порциями, но часто. Проводить контроль за своевременным приемом пациентом лекарственных препаратов. Обеспечить уход за полостью рта пациента
 Снижение аппетита из-за Провести беседу с пациентом и его депрессии и высокой температуры родственниками о необходимости тела; риск снижения массы тела. полноценного питания. Создать благоприятную обстановку во время еды. Нарушение целостности слизистой оболочки полости рта Проводить тщательный уход за полостью рта пациента Нарушение целостности кожи из-за нарушения трофики Проводить тщательный уход за кожей пациента Риск инфицирования кожи из-за расчесов и «заед» в уголках рта Провести беседу с пациентом о значении гигиены. Следить за ежедневным приемом душа (возить на каталке). Незнание положения, облегчающего дыхание во время сна; риск развития пневмонии из-за снижения иммунитета и гиповентиляции Обучить пациента занимать положение Фаулера (полулежа полусидя). Обеспечить второй подушкой или поднять изголовье кровати. Обучить дыхательным упражнениям
Снижение аппетита из-за Провести беседу с пациентом и его депрессии и высокой температуры родственниками о необходимости тела; риск снижения массы тела. полноценного питания. Создать благоприятную обстановку во время еды. Нарушение целостности слизистой оболочки полости рта Проводить тщательный уход за полостью рта пациента Нарушение целостности кожи из-за нарушения трофики Проводить тщательный уход за кожей пациента Риск инфицирования кожи из-за расчесов и «заед» в уголках рта Провести беседу с пациентом о значении гигиены. Следить за ежедневным приемом душа (возить на каталке). Незнание положения, облегчающего дыхание во время сна; риск развития пневмонии из-за снижения иммунитета и гиповентиляции Обучить пациента занимать положение Фаулера (полулежа полусидя). Обеспечить второй подушкой или поднять изголовье кровати. Обучить дыхательным упражнениям
 Трудности с мочеиспусканием из-за невозможности посещать туалет; риск инфицирования мочеполовой системы Провести беседу с пациентом о необходимости регулярного опорожнения мочевого пузыря. Подавать судно (мочеприемник) в постель по мере необходимости. Подмывать после каждого мочеиспускания Страх смерти из-за отсутствия полной информации о стернальной пункции и химиотерапии Провести беседу с пациентом. Оказать психологическую поддержку Ограничение подвижности из-за Ежедневно проводить слабости, головокружения, гигиенический уход по примерному высокой температуры тела; стандарту дефицит самоухода и зависимость из-за ограниченной подвижности
Трудности с мочеиспусканием из-за невозможности посещать туалет; риск инфицирования мочеполовой системы Провести беседу с пациентом о необходимости регулярного опорожнения мочевого пузыря. Подавать судно (мочеприемник) в постель по мере необходимости. Подмывать после каждого мочеиспускания Страх смерти из-за отсутствия полной информации о стернальной пункции и химиотерапии Провести беседу с пациентом. Оказать психологическую поддержку Ограничение подвижности из-за Ежедневно проводить слабости, головокружения, гигиенический уход по примерному высокой температуры тела; стандарту дефицит самоухода и зависимость из-за ограниченной подвижности




